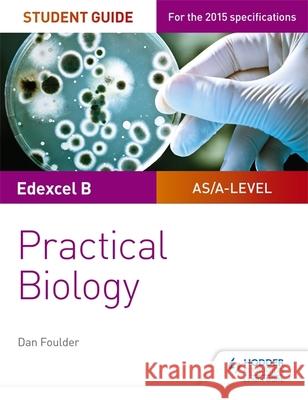
Edexcel A-level Biology Student Guide: Practical Biology Dan Foulder 9781471885167 Hodder Education

» książki » Nature - Regional
 |
Step-by-Step Guide to Foraging Edible Wild Plants: The 38 Mountain West Plants You Need to Know
ISBN: 9781960234025 / Angielski / Miękka / 182 str. Termin realizacji zamówienia: ok. 5-8 dni roboczych. |
cena:
57,53 |
 |
Badlands of the American West: A Primer
ISBN: 9781469954875 / Angielski / Miękka / 58 str. Termin realizacji zamówienia: ok. 5-8 dni roboczych. A geographer presents an introduction to the badlands environments of the western United States. The physical geography and geology of these spectacular environments is presented in plain language (Reading level is Age 12 to Adult) and is fully illustrated (37 full-color photos, diagrams, and maps). The book is aimed at travelers and teachers who would like a concise overview of the processes that sculpted these dry country landscapes. A glossary is included. Regions featured are: Little Missouri River Badlands of North Dakota; White River Badlands of South Dakota and Nebraska, Paint Mines of...
A geographer presents an introduction to the badlands environments of the western United States. The physical geography and geology of these spectacul...
|
cena:
57,94 |
 |
Wild Berries & Fruits Field Guide of the Rocky Mountain States
ISBN: 9781591932819 / Angielski / Miękka / 336 str. Termin realizacji zamówienia: ok. 5-8 dni roboczych. Now you can identify wild berries and fruits. Learn what's edible and what to avoid with this easy-to-use field guide. The species in the book are organized by color, then by form, so when you see something in the field, you'll know just where to look. Full-page photos and insets show each plant's key identification points, while detailed descriptions give you the information you need to know. Teresa Marrone has been gathering and preparing wild edibles for more than 20 years. Let her share that experience with you.
Now you can identify wild berries and fruits. Learn what's edible and what to avoid with this easy-to-use field guide. The species in the book are org...
|
cena:
58,55 |
 |
Great Alaska Nature Factbook: A Guide to the State's Remarkable Animals, Plants, and Natural Features
ISBN: 9780882408385 / Angielski / Miękka / 224 str. Termin realizacji zamówienia: ok. 5-8 dni roboczych. The Great Alaska Nature Factbook describes the diversity of plants and animals in Alaska. Illustrated with line drawings, the text has entries for the 105 species of mammals, nearly 300 birds, and 1,500 species of plants. The author also provides an overview of the six regions and the natural features such as the Bering Land Bridge, mineral deposits, and hot springs. It is a field guide or minature encyclopedia of facts and trivia about Alaska. Index and Further readings are also included.
The Great Alaska Nature Factbook describes the diversity of plants and animals in Alaska. Illustrated with line drawings, the text has entries for the...
|
cena:
58,71 |
 |
The Natural History of the Edwards Plateau: The Texas Hill Country
ISBN: 9781623498597 / Angielski / Miękka / 84 str. Termin realizacji zamówienia: ok. 5-8 dni roboczych. |
cena:
59,56 |
 |
The Natural History of the Trans-Pecos: Desert Legends, Rugged Grandeur, and the Big Bend
ISBN: 9781623498610 / Angielski / Miękka / 84 str. Termin realizacji zamówienia: ok. 5-8 dni roboczych. |
cena:
59,56 |
|
Edexcel A-level Biology Student Guide: Practical Biology
ISBN: 9781471885167 / Angielski / Miękka / 104 str. Termin realizacji zamówienia: ok. 5-8 dni roboczych. Ensure your students get to grips with the core practicals and develop the skills needed to succeed with an in-depth assessment-driven approach that builds and reinforces understanding; clear summaries of practical work with sample questions and answers help to improve exam technique in order to achieve higher grades.
Ensure your students get to grips with the core practicals and develop the skills needed to succeed with an in-depth assessment-driven approach that b...
|
cena:
60,13 |
 |
OCR A-level Biology Student Guide: Practical Biology
ISBN: 9781471885617 / Angielski / Miękka / 104 str. Termin realizacji zamówienia: ok. 5-8 dni roboczych. Ensure your students get to grips with the core practicals and develop the skills needed to succeed with an in-depth assessment-driven approach that builds and reinforces understanding; clear summaries of practical work with sample questions and answers help to improve exam technique in order to achieve higher grades.
Ensure your students get to grips with the core practicals and develop the skills needed to succeed with an in-depth assessment-driven approach that b...
|
cena:
60,13 |
 |
AQA A-level Biology Student Guide: Practical Biology
ISBN: 9781471885587 / Angielski / Miękka / 104 str. Termin realizacji zamówienia: ok. 5-8 dni roboczych. Ensure your students get to grips with the core practicals and develop the skills needed to succeed with an in-depth assessment-driven approach that builds and reinforces understanding; clear summaries of practical work with sample questions and answers help to improve exam technique in order to achieve higher grades.
Ensure your students get to grips with the core practicals and develop the skills needed to succeed with an in-depth assessment-driven approach that b...
|
cena:
60,13 |
 |
The Elephant Whisperer: Learning About Life, Loyalty and Freedom From a Remarkable Herd of Elephants
ISBN: 9781509838530 / Angielski / Miękka / 400 str. Termin realizacji zamówienia: ok. 5-8 dni roboczych. A charming, moving account of one man's race to save a herd of elephants.
A charming, moving account of one man's race to save a herd of elephants.
|
cena:
60,91 |
 |
Superstition Mountains Photos And Points of interest
ISBN: 9781475214215 / Angielski / Miękka / 48 str. Termin realizacji zamówienia: ok. 5-8 dni roboczych. Full color photos and Topographic Maps of points of interest in the Superstition Mountains of Arizona.
Full color photos and Topographic Maps of points of interest in the Superstition Mountains of Arizona.
|
cena:
61,48 |
 |
The Other Side of The Island: : 52 Spots to Explore Long Island's Natural Places
ISBN: 9781499260625 / Angielski / Miękka / 306 str. Termin realizacji zamówienia: ok. 5-8 dni roboczych. |
cena:
61,48 |
 |
A Journey of Discovery: Monroe County Outdoors
ISBN: 9781535053426 / Angielski / Miękka / 280 str. Termin realizacji zamówienia: ok. 5-8 dni roboczych. Wildlife biologist Terry Johnson has written a weekly column for the Monroe County Reporter for more than twenty-five years. These columns have taken readers on a journey of discovery that has wound its way through backyards and the countryside. Each week his readers eagerly await his next column to see where the journey leads them next. Johnson has now published a collection of more than seventy of his columns. These columns are packed with fascinating glimpses into the lives of the plants and animals that live in middle Georgia. Through Johnson's work readers are... Wildlife biologist Terry Johnson has written a weekly column for the Monroe County Reporter for more than twenty-five years. These columns h... |
cena:
61,48 |
 |
Split Rock Wildway: Scouting the Adirondack Park's Most Diverse Wildlife Corridor
ISBN: 9780996787079 / Angielski / Miękka / 170 str. Termin realizacji zamówienia: ok. 5-8 dni roboczych. |
cena:
61,69 |
 |
A Daybook for January in Yellow Springs, Ohio: A Memoir in Nature
ISBN: 9781728671352 / Angielski / Miękka / 198 str. Termin realizacji zamówienia: ok. 5-8 dni roboczych. |
cena:
61,69 |
 |
In Antarctica, You'll Find Me: A Story of Adventure Discovering Creatures of Antarctica
ISBN: 9781727421064 / Angielski / Miękka / 30 str. Termin realizacji zamówienia: ok. 5-8 dni roboczych. |
cena:
61,69 |
 |
Salmon Fishing on the Nipisiguit
ISBN: 9781499505092 / Angielski / Miękka / 64 str. Termin realizacji zamówienia: ok. 5-8 dni roboczych. |
cena:
61,69 |
 |
In the Rainforest, You'll Find Me: A Story of Adventure Discovering Creatures of the Rainforest
ISBN: 9781697406160 / Angielski / Miękka / 30 str. Termin realizacji zamówienia: ok. 5-8 dni roboczych. |
cena:
61,69 |
 |
The Great Flood: Travels Through a Sodden Landscape
ISBN: 9780330420280 / Angielski / Miękka / 192 str. Termin realizacji zamówienia: ok. 5-8 dni roboczych. A BBC Radio 4 'Book of the Week'. Flooding has always threatened the rainy, wind-swept islands of the United Kingdom, but it is becoming more frequent and more severe. Combining travel writing and reportage with readings of history, literature and myth, Edward Platt explores the way floods have shaped the physical landscape of Britain and left their mark on its inhabitants. During the course of two years, which coincided with the record-breaking floods of the winter of 2013-14, Platt travelled around the country, visiting places that had flooded and meeting the people affected. He...
A BBC Radio 4 'Book of the Week'. Flooding has always threatened the rainy, wind-swept islands of the United Kingdom, but it is becoming more frequ...
|
cena:
62,70 |














